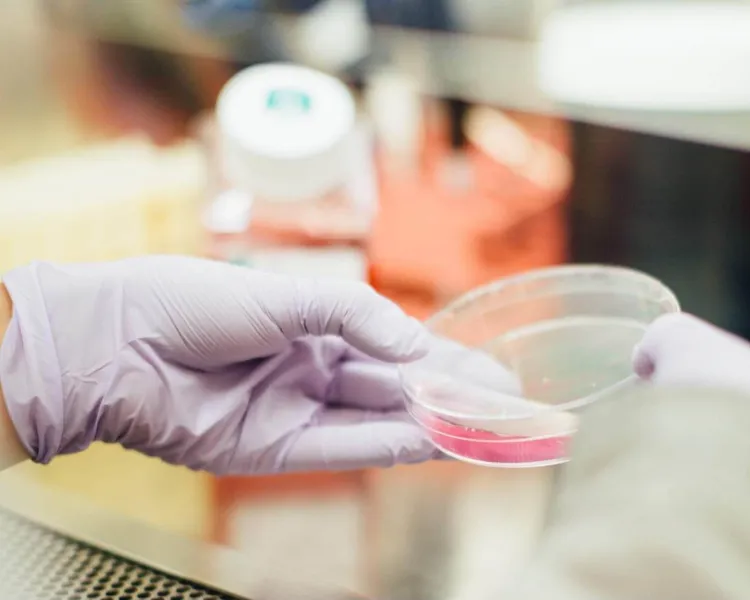
aafd3383684fc56037443f9e2961f844.jpeg

Testări gratuite Babeş-Papanicolau și HPV la Cluj-Napoca! Cine poate beneficia
Vești bune pentru clujence! Din data de 25 ianuarie, își pot face testări gratuite Babeş-Papanicolau și HPV la cabinetele medicale de la parterul Căminului Studențesc Sport XXI. Atunci când este făcut în mod regulat, testul Babeș-Papanicolau este cea mai bună metodă pentru a preveni cancerul de col uterin.
Testele care detectează HPV, precum și cel Papanicolau, ajută medicul să aprecieze măsura în care există risc ca femeia respectivă să dezvolte cancer sau nu. Dacă testul pentru HPV iese pozitiv, atunci va fi nevoie de investigații suplimentare, însă acest fapt rămâne exclusiv la latitudinea medicului specialist.
„Institutul Oncologic „Prof. Dr. Ion Chiricuţă” Cluj-Napoca în parteneriat cu universitatea noastră și Sindicatul UBB organizează campania de testare gratuită Babeș Papanicolau tuturor femeilor cu vârsta între 24 - 29 ani sau HPV tuturor femeilor cu vârsta între 30 - 64 ani.”, anunță UBB.

Condiții de eligibilitate
- Domiciliul într-unul dintre județele: Cluj, Bihor, Bistrița-Năsăud, Maramureș, Satu-Mare, Sălaj
- Vârsta cuprinsă între 29-24 de ani pentru testul Babeș-Papanicolau
- Vârsta cuprinsă între 30-64 de ani pentru testul HPV
- Fără histerectomie totală
- Fără un diagnostic confirmat de cancer de col uterin
- Asigurate sau neasigurate
- Pentru aceste testări nu aveți nevoie de bilet de trimitere

0 Comentarii